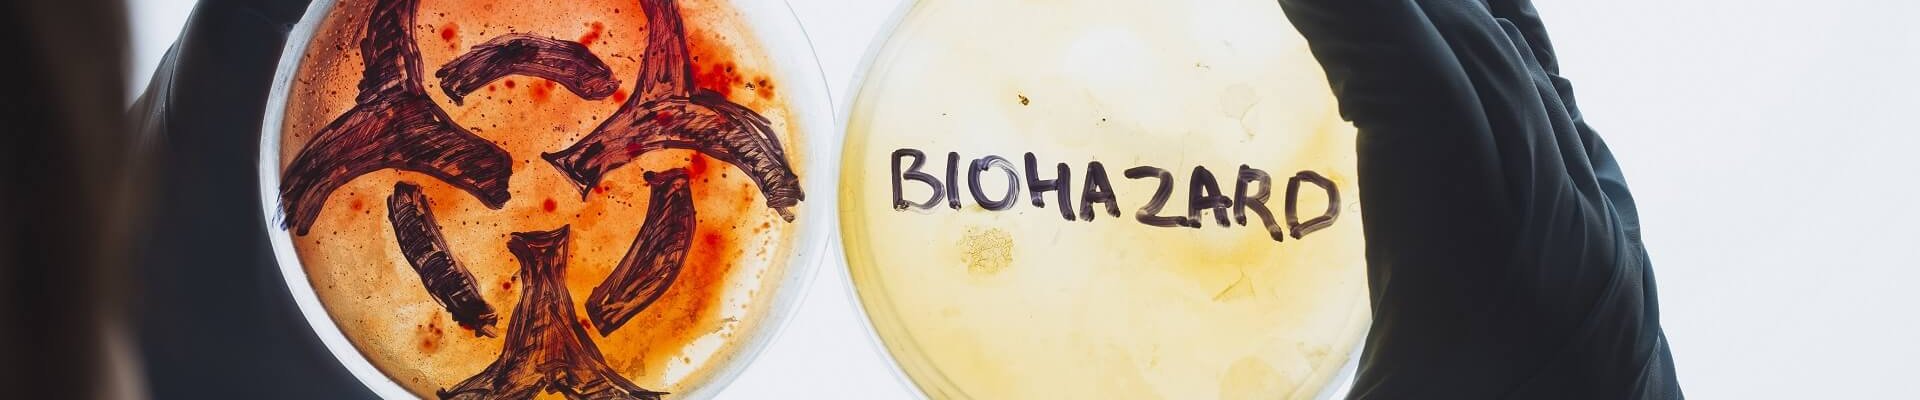

Primer convenio internacional centrado en los peligros biológicos en el entorno laboral
En el marco de la 113ª Conferencia Internacional del Trabajo celebrada en Ginebra en junio de 2025, la OIT ha adoptado el Primer Convenio Internacional centrado específicamente en los peligros biológicos en el entorno laboral, un instrumento normativo que busca responder al creciente impacto de los agentes biológicos en la salud y seguridad de los trabajadores a nivel mundial, tomando como base los principios del trabajo decente y un entorno seguro y saludable como derecho fundamental.
El convenio define como riesgos biológicos a todos los microorganismos (incluidos modificados genéticamente), toxinas, alérgenos e irritantes de origen vegetal o animal, que puedan causar enfermedades o lesiones por exposición laboral. Su ámbito de aplicación se extiende a todos los sectores y trabajadores, salvo exclusiones justificadas por los Estados Miembros.
Entre sus principales pilares, el texto insta a los países a integrar los riesgos biológicos en sus políticas nacionales de seguridad y salud en el trabajo, y a fomentar la coordinación interinstitucional, especialmente con los sistemas de salud pública. El Convenio también promueve la evaluación sistemática de riesgos, el desarrollo de medidas preventivas y planes de respuesta ante emergencias, y la adopción de disposiciones específicas para sectores de alto riesgo como salud, agricultura, laboratorios, servicios funerarios, entre otros.
Los empleadores, por su parte, tienen la obligación de garantizar entornos laborales libres de riesgos biológicos en la medida de lo posible, mediante la evaluación, eliminación o control jerarquizado de peligros, el suministro de equipos de protección adecuados, la formación y la vigilancia sanitaria de los trabajadores. A su vez, los trabajadores adquieren derechos clave, como ser informados, participar en la toma de decisiones, negarse a continuar una actividad peligrosa, y acceder a medidas de rehabilitación y protección frente a represalias.
El texto se complementa con una recomendación que detalla criterios técnicos, sectores prioritarios y grupos especialmente vulnerables (embarazadas, personas inmunodeprimidas, migrantes, etc.). Además, promueve una cultura preventiva transversal